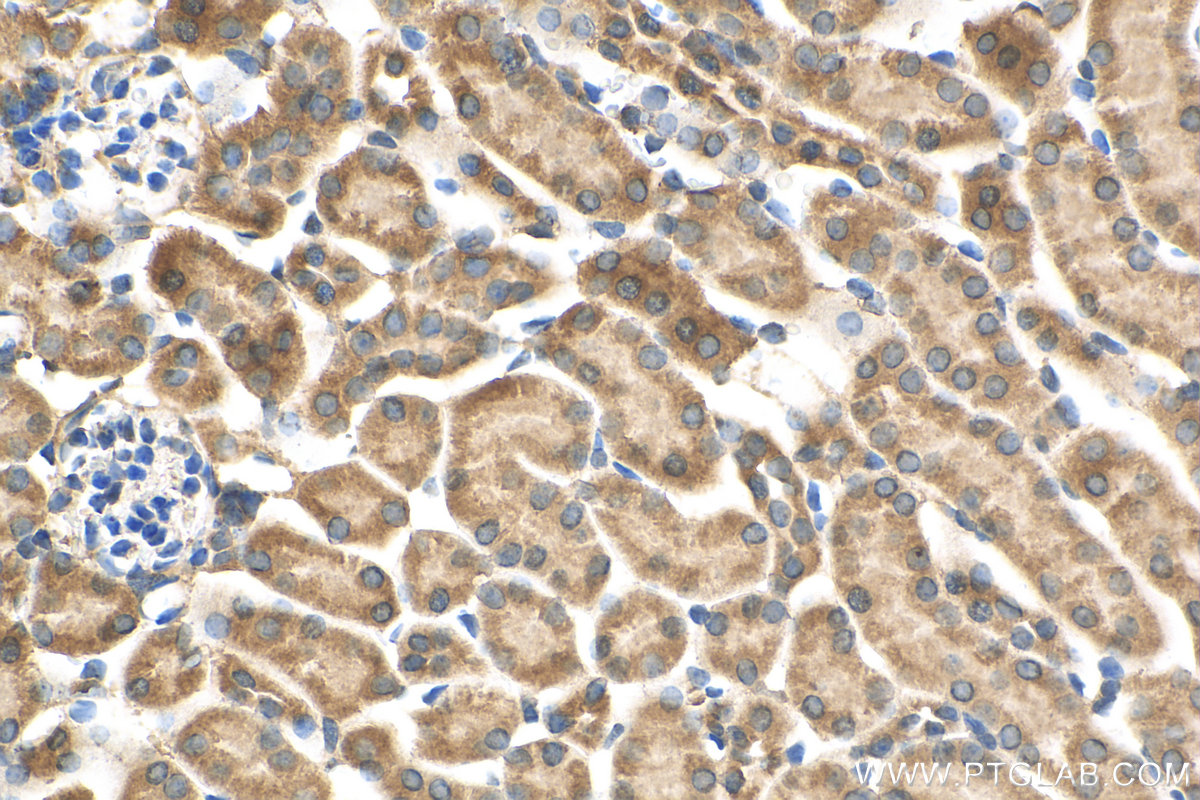

验证数据展示
经过测试的应用
| Positive IHC detected in | mouse testis tissue, human osteosarcoma tissue, human testis tissue, rat testis tissue, mouse kidney tissue Note: suggested antigen retrieval with TE buffer pH 9.0; (*) Alternatively, antigen retrieval may be performed with citrate buffer pH 6.0 |
| Positive IF/ICC detected in | U2OS cells, NIH/3T3 cells |
| Positive FC (Intra) detected in | NIH/3T3 cells, U2OS cells |
推荐稀释比
| 应用 | 推荐稀释比 |
|---|---|
| Immunohistochemistry (IHC) | IHC : 1:50-1:500 |
| Immunofluorescence (IF)/ICC | IF/ICC : 1:200-1:800 |
| Flow Cytometry (FC) (INTRA) | FC (INTRA) : 0.40 ug per 10^6 cells in a 100 µl suspension |
| It is recommended that this reagent should be titrated in each testing system to obtain optimal results. | |
| Sample-dependent, Check data in validation data gallery. | |
发表文章中的应用
| IHC | See 109 publications below |
| IF | See 111 publications below |
产品信息
23418-1-AP targets Osteocalcin/OCN in IHC, IF/ICC, FC (Intra), ELISA applications and shows reactivity with human, mouse, rat samples.
| 经测试应用 | IHC, IF/ICC, FC (Intra), ELISA Application Description |
| 文献引用应用 | IHC, IF |
| 经测试反应性 | human, mouse, rat |
| 文献引用反应性 | human, mouse, rat, pig, canine, goat |
| 免疫原 |
CatNo: Ag20065 Product name: Recombinant human Osteocalcin protein Source: e coli.-derived, PGEX-4T Tag: GST Domain: 24-100 aa of BC113432 Sequence: KPSGAESSKGAAFVSKQEGSEVVKRPRRYLYQWLGAPVPYPDPLEPRREVCELNPDCDELADHIGFQEAYRRFYGPV 种属同源性预测 |
| 宿主/亚型 | Rabbit / IgG |
| 抗体类别 | Polyclonal |
| 产品类型 | Antibody |
| 全称 | bone gamma-carboxyglutamate (gla) protein |
| 别名 | BGLAP, Osteocalcin, BGP, Bone Gla protein, Gamma-carboxyglutamic acid-containing protein |
| 计算分子量 | 100 aa, 11 kDa |
| GenBank蛋白编号 | BC113432 |
| 基因名称 | Osteocalcin |
| Gene ID (NCBI) | 632 |
| RRID | AB_2879275 |
| 偶联类型 | Unconjugated |
| 形式 | Liquid |
| 纯化方式 | Antigen affinity purification |
| UNIPROT ID | P02818 |
| 储存缓冲液 | PBS with 0.02% sodium azide and 50% glycerol, pH 7.3. |
| 储存条件 | Store at -20°C. Stable for one year after shipment. Aliquoting is unnecessary for -20oC storage. |
背景介绍
Osteocalcin is a small, highly conserved molecule associated with mineralization of bone matrix. Osteocalcin is specifically expressed in osteoblasts and is the most abundant non-collagenous protein in bone. It regulates the dynamics of new bone formation and bone resorption by interaction with vitamin D, and by influencing the differentiation of osteoblasts. Osteocalcin is also involved in the posttranslational targeting of vitamin K-dependent gamma-carboxylation, which controls blood coagulation.
实验方案
| Product Specific Protocols | |
|---|---|
| FC protocol for Osteocalcin/OCN antibody 23418-1-AP | Download protocol |
| IF protocol for Osteocalcin/OCN antibody 23418-1-AP | Download protocol |
| IHC protocol for Osteocalcin/OCN antibody 23418-1-AP | Download protocol |
| Standard Protocols | |
|---|---|
| Click here to view our Standard Protocols |
发表文章
| Species | Application | Title |
|---|---|---|
Adv Mater Supramolecular Hydrogel with Ultra-Rapid Cell-Mediated Network Adaptation for Enhancing Cellular Metabolic Energetics and Tissue Regeneration | ||
Bioact Mater Ultrasound-generated bubbles enhance osteogenic differentiation of mesenchymal stromal cells in composite collagen hydrogels | ||
Bioact Mater 3D Printed Biomimetic Metamaterials with Graded Porosity and Tapering Topology for Improved Cell Seeding and Bone Regeneration | ||
ACS Nano Nanotopography Sequentially Mediates Human Mesenchymal Stem Cell-Derived Small Extracellular Vesicles for Enhancing Osteogenesis. | ||
Nat Commun Optogenetic activation of mechanical nociceptions to enhance implant osseointegration | ||
Adv Sci (Weinh) POSTN-Mediated Interplay of M1 Polarized Macrophage with Tendon-Derived Stem Cells to Drive Traumatic Heterotopic Ossification Formation through PTK7/ATK Signaling |